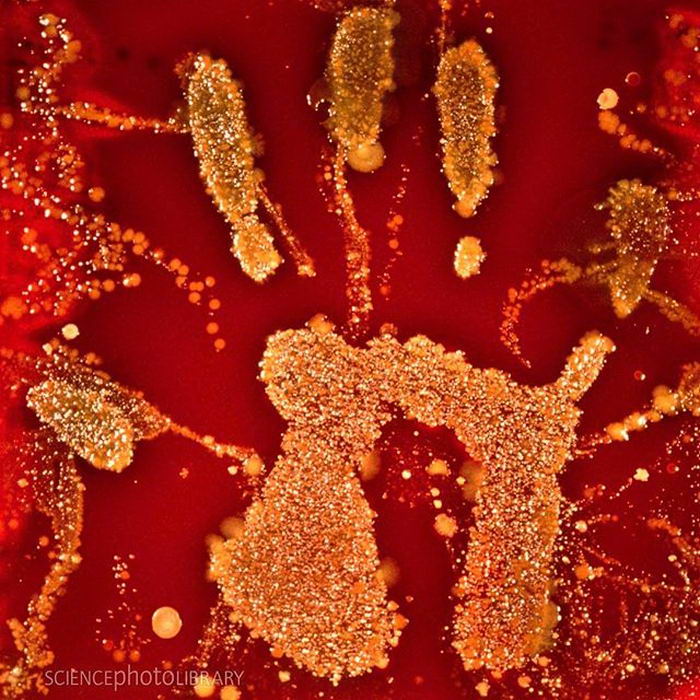
|15张引人入胜的迷人照片，人体到底有多神奇？都是知识点

|15张引人入胜的迷人照片,人体到底有多神奇?都是知识点

文章图片

文章图片

文章图片

文章图片

文章图片
文章图片

文章图片

我们经常对周围的有趣生物感到兴奋 , 以至于我们忘记了人类是地球上最神奇的生物 。 即使是我们自己的身体 还有许多我们以前不知道的故事 。 今天【全球不可思议】想带大家去看看有趣的图片 。 我向您保证 , 它比您想象的还要令人惊奇 。
【|15张引人入胜的迷人照片,人体到底有多神奇?都是知识点】1.这约2.26公斤的脂肪
2.带有深疤痕的皮肤不会产生汗水 。 因此 , 灰尘和污渍不会在该区域粘附在皮肤上
3.在我们的骨头里 , 似乎不像您想象中的那样
4.我妻子生完孩子后头发的颜色自然变了
5.胖男人的X光(左图) , 与身体正常(右图)的人相比
6.牙齿的根是什么样的呢?这就是为什么很难拔掉的原因
7.心脏通过清洁细胞的过程 , 直到变白 , 叫做幽灵之心
8.图像之间的比较 , 大象脚和人脚 , 这表明大象脚将具有非常厚的骨骼支撑区域
9.如果人类只剩下血管 , 那我们看起来就像这样的
10.这张照片向我们展示了恒牙长大前的状态
11.这份笔迹表明 , 我们的身体拥有数百万个微生物 , 它们幸福地生活在我们手上
12 , 专业自行车手的腿 , 比赛结束后
13 , 来自土耳其的世界最高男人苏丹·科森(Sultan Kosen)身高251厘米
14.您能与自己母亲的脸重合吗
15.我们胃中的酸很浓 , 直到能够腐蚀金属硬币
如果您对这些迷人的照片感兴趣 , 请在评论区留言一起讨论 , 如果您还想观看更多 , 请点击头像进入查看
推荐阅读
- 毒蛇|全球最“值钱”的蛇,外表艳丽迷人,即便再有钱也买不到
- 华为mate40|让更多人买得起!华为Mate40廉价版入网:这外观太迷人
- 小辰魔法师|嫣然一笑的迷人气质,尽显女性美的时尚感,迷人的泳衣小姐姐
